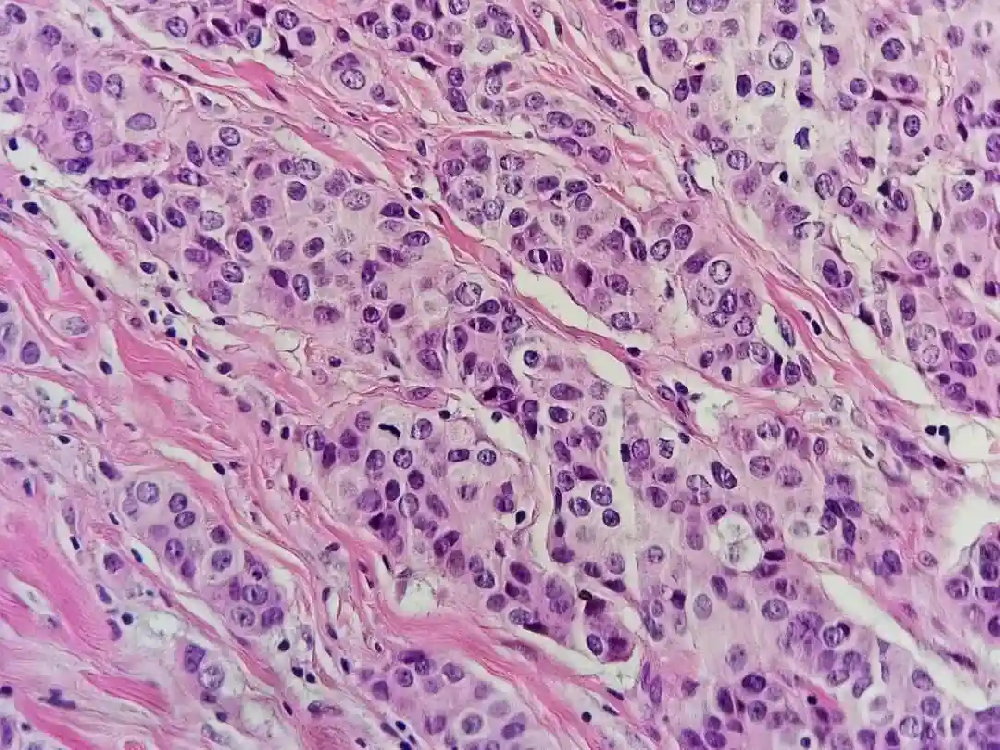
乳腺癌病理報告解讀：ER、PR、Ki-67、HER-2 等指標全解析

肺癌的治療方式有哪些?如何量身定制方案? 肺癌作為高發惡性腫瘤,随着醫學發展,肺癌治療手段愈發豐富。......【查看全文】
乳腺癌早期有哪些症狀?早發現早治療是關鍵 乳腺癌近年來發病率持續上升,若能在早期發現并及時治療,其治愈率會大幅提高。......【查看全文】
結直腸癌 TNM 分期及解讀 结直肠癌 TNM 分期及解读......【查看全文】
乳腺癌病理報告解讀:ER、PR、Ki-67、HER-2 等指標全解析 乳腺癌是女性常見惡性腫瘤,發病率佔全身惡性腫瘤的 7%~10%,其中免疫組化結果是核心,可明確分子類型、指導治療並提示預後。......【查看全文】
哪些癌症適用放療?這些情況不適合 在腫瘤治療的常用手段中,放療與手術、化療、中醫治療同樣重要。......【查看全文】
宮頸癌切除子宮就安全了嗎?這些注意事項要牢記 頸癌作爲女性生殖系統中常見的惡性腫瘤之一,其危害程度不容小覷,宮頸癌的治療是一個系統工程,切除子宮只是其中一環,後續的綜合治療、康復護理與預防措施同樣重要。......【查看全文】
肝癌新療法釔 - 90:常見疑問一次性解答 肝癌是全球高發惡性腫瘤,我國發病率和死亡率居高不下。,近些年來,肝臟惡性腫瘤的局部治療取得了一些明顯的進步,釔90放射性栓塞術是融合了腫瘤近程放療和介入治療的一種創新療法,釔90放射性微球治療肝臟惡性腫瘤具有安全、有效的優勢,以下針對患者常見疑問進行解答。......【查看全文】
肝癌的形成與這些誘因密切相關 肝癌作爲一種高發的惡性腫瘤,其形成並非一蹴而就,它的發展通常遵循 “正常肝細胞 - 肝損傷 - 肝纖維化 - 肝硬化 - 肝癌” 的路徑,整個過程可能持續數年至數十年。......【查看全文】